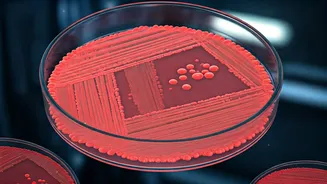
Shigella Scourge: Why Little Ones Face the Biggest Risk

A Health Hurdle Revealed
Actor Varun Dhawan recently shared a deeply personal account of a significant health challenge his young daughter, Vamika, faced shortly after her birth
in February 2021. Alongside his wife Natasha Dalal, Dhawan navigated the diagnosis of Developmental Dysplasia of the Hip (DDH). This condition, characterized by an improperly formed hip socket, can lead to a loose or dislocated hip joint. The revelation offered a glimpse into the private struggles of a celebrity family and highlighted a lesser-discussed medical issue that impacts many infants. Dhawan's openness serves as a beacon for awareness and a testament to the support systems available for such conditions.
The Path to Healing
To address Vamika's DDH diagnosis, a critical treatment phase was implemented: a cast that required her to be in it for a considerable duration of two and a half months. This extended period in a cast is a common therapeutic approach for DDH, designed to stabilize the hip joint and promote proper development of the socket. The actor conveyed his profound gratitude towards the dedicated medical professionals who guided them through this complex period, underscoring the collaborative effort between parents and healthcare providers. This period undoubtedly tested the family's resilience, but their commitment to Vamika's well-being remained unwavering throughout the treatment.
Importance of Early Detection
Varun Dhawan's candid discussion about Vamika's health journey strongly emphasizes the paramount importance of early diagnosis and prompt treatment for Developmental Dysplasia of the Hip. Recognizing the signs and seeking medical advice at the earliest stage can significantly alter the course of treatment and improve outcomes for affected infants. This awareness is crucial for parents, who play a vital role in their child's health. Dhawan's experience serves as an encouragement for others to remain vigilant and proactive, ensuring that potential issues are identified and addressed swiftly, thereby safeguarding the child's long-term mobility and development. The actor's willingness to share underscores a broader message of hope and empowerment for families facing similar health challenges.